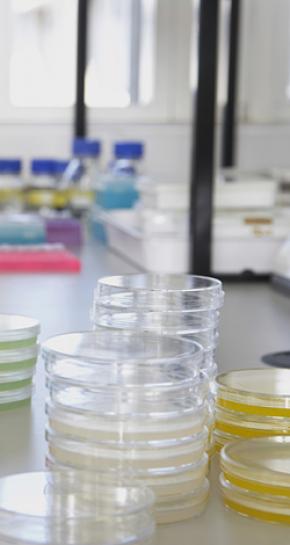

‘In mijn kweekschaal zie ik nu al mogelijkheden’
Leestijd: 4 minuten
De jonge onderzoeker Tom Harrijvan (27) doet sinds 2018 promotieonderzoek naar de mogelijkheden van immuuntherapie bij darmkanker. Voor zijn onderzoek heeft hij de Pieter De Mulder Award gekregen. Die prijs stelt hem in staat om drie maanden kennis op te doen in het buitenland. ‘Geweldig, want daarmee kan ik mijn oncologische research verder verdiepen.’

Tom Harrijvan is overduidelijk blij met het winnen van de Pieter De Mulder Award. Hij is vrolijk en vertelt enthousiast over wat de prijs voor hem betekent.
De onderzoeker weet al precies waar hij naartoe wil: naar Amerika
“Ik kan hiermee mijn promotieonderzoek verder verdiepen. Ik ben de commissie die heeft besloten mij deze award toe te kennen, erg dankbaar. Met deze prijs is het voor mij mogelijk om kennis op te doen in het buitenland. Die ervaring kan mijn onderzoek verder helpen.”
De onderzoeker weet al precies waar hij naartoe wil: naar Amerika. “Daar zijn de onderzoeksgroepen expert op het gebied van een nieuwe techniek: CRISPR/Cas. Die tool wordt wereldwijd gezien als een grote doorbraak in de mogelijkheid van het aanpassen van DNA.”
Tom wil de nieuwe techniek tijdens zijn ervaringsstage in Amerika beter leren kennen. “Ik kan de techniek namelijk goed toepassen binnen mijn eigen onderzoek.”
Inmiddels heeft Tom de aanvraag richting Amerika al uitstaan. Nu is het wachten op groen licht. Tom behaalde in 2017 zijn masterdiploma Geneeskunde en in 2018 Biomedische Wetenschappen aan het Leids Universitair Medisch Centrum (LUMC). Daarna begon hij aan zijn promotieonderzoek onder toezicht van dr. Luuk Hawinkels, dr. Els Verdegaal en prof. dr. James Hardwick van de afdelingen Maag- Darm- en Leverziekten en Medische Oncologie.
Hij doet onderzoek naar ‘de immuunregulerende rol van kanker-geassocieerde fibroblasten in gastro-intestinale maligniteiten’.
“Ik snap dat mijn onderzoek om enige uitleg vraagt”, zegt Tom met een lach. “Met mijn onderzoek houd ik mij bezig met steuncellen en immuuncellen. De steuncellen, fibroblasten genoemd, komen net als de immuuncellen in heel ons lichaam voor. Alleen de fibroblasten in de nabijheid van een tumor, kunnen voor het karretje van de tumor worden gespannen. Ze helpen dan de tumor verder uit te groeien.”
“Een manier waarop een fibroblast dit kan doen, is het afremmen van het afweersysteem. Wij vermoeden dat een fibroblast negatieve signalen afgeeft. Daardoor kan een immuuncel een tumor niet meer adequaat opruimen.”
'Ja, ons immuunsysteem is in potentie in staat om kwaadaardige cellen zelf op te ruimen'
Signalen begrijpen
“Onze theorie is dat we de negatieve signalen van een steuncel moeten begrijpen. Dan kunnen nadenken over de mogelijkheden om die signalen te remmen. Het afweersysteem wordt daarmee weer in staat gesteld de tumor op te ruimen.”
Daarmee zegt Tom dat ons lichaam dus in principe prima in staat is om slechte cellen te doden. “Ja, ons immuunsysteem is in potentie in staat om kwaadaardige cellen zelf op te ruimen. Dat zie ik in het klein in een kweekschaal gebeuren”, vertelt hij.
“Daarom onderzoeken we hoe een steuncel een immuunreactie afremt. Want hoe kan het dat een immuuncel in het ene geval een tumor wel kan aanvallen en in het andere geval niet? We weten dat de steuncel daarin een belangrijke rol. Die geeft bepaalde signalen af en die moeten we zien te herkennen.”
Deel puzzel oplossen
Die puzzel probeert Tom nu op te lossen. Zijn promotieonderzoek loopt nog tot half 2021 met een mogelijk verlenging van een jaar. “Ik heb nog even. In die tijd hoop ik dat we een deel van de puzzel hebben opgelost.”
Natuurlijk hoopt Tom het liefst dat het onderzoek een revolutionaire nieuwe behandelmethode voor kanker oplevert. “Dat is alleen niet realistisch”, zegt hij. “Wat we wel voor elkaar kunnen krijgen, is begrijpen hoe een steuncel ervoor zorgt dat een immuuncel een tumor niet aanpakt. Als we dat weten, kunnen we manieren bedenken om in dit proces in te grijpen.”

Veel in het lab
Ongeveer 60 tot 70 procent van zijn tijd brengt Tom door in het laboratorium. “Ik werk daar met verschillende celtypes. Het celmateriaal krijgen we met toestemming van patiënten met darmkanker. Op de scopie-afdeling of na een operatie wordt er ook een stukje weefsel weggehaald voor ons onderzoek.”
Al die verschillende cellen doet Tom letterlijk in een kweekschaal. “Ik haal ze uit elkaar, doe ze bij elkaar. Doe er stofjes bij, haal er stofjes af. Ik kijk naar de reacties. Er zijn heel veel mogelijkheden.”
Tom legt uit dat ze op een specifieke signaleringsroute inzoomen, waarvan al langer bekend is dat deze een belangrijke rol speelt in dikkedarmkanker. “Tumoren van patiënten met dikkedarmkanker maken bepaalde stoffen aan”, legt hij uit. “We proberen dat proces na te doen in een kweekschaaltje. Daardoor zien we onder meer wat het effect is van deze stoffen op de functie van fibroblasten.
Met al die informatie kunnen we proberen de immuunreactie daarna juist positief te beïnvloeden. Op die manier kan de immuuncel de tumorcel dus wel doden. Door de signaalroutes te identificeren, kun je ze vervolgens manipuleren.”
‘Wij moeten snappen waarom een immuuncel niet reageert’
Tom hoopt dat zijn onderzoek meer inzicht gaat opleveren in hoe het immuunsysteem in dikkedarmkanker wordt geremd. “We zien bij andere vormen van kanker, zoals huid- en longkanker, dat immuuntherapie bij een deel van de patiënten effectief is en daar nu ook steeds meer wordt toegepast.”
Bij dikkedarmkanker is er op dit moment slechts een kleine groep patiënten die mogelijk baat heeft bij immuuntherapie. De immuuntherapie wordt bij deze vorm van kanker dan ook niet vaak toegepast.
“Hopelijk krijgen we met ons onderzoek aanwijzingen om het immuunsysteem toch in staat te stellen om darmtumoren te herkennen en op te ruimen. Dan zouden we in de toekomst darmtumoren kunnen proberen te behandelen met immuuntherapie.”
Gespecialiseerd arts worden
De overige 30 tot 40 procent van zijn tijd brengt Tom achter zijn computer door. “Dan werk ik de resultaten uit, schrijf ik artikelen en doe ik aanvragen om ons onderzoek te kunnen blijven financieren.”
“Ja, ik voel me soms best een einzelgänger. Natuurlijk werk ik samen met de mensen in ons onderzoeksteam en heb ik contact met de maag-darm-leverartsen. Toch zit ik veel zelf te puzzelen.”
Contact met de patiënten zelf heeft hij nu niet echt. “Ik zie ze wel bij de scopie, maar ik heb dan niet zelf contact.” Als Tom naar de toekomst kijkt, dan wil hij wel meer met patiënten omgaan.
Focus op oncologie
“Ik hoop over een jaar of tien maag-darm-leverarts te zijn bij een universitair centrum. Ik wil dan mijn focus hebben op oncologie, op tumoren. En ik wil actief betrokken te zijn bij onderzoek.” Vanuit zijn rol als gespecialiseerd arts hoopt Tom dan nauw betrokken te zijn bij het uitrollen van nieuwe immuuntherapieën.
“Ook als mijn huidige onderzoek niet dé doorbraak oplevert, dan heb ik in elk geval zelf jaren ervaring opgedaan in het laboratorium. Dan weet ik wat er mogelijk is op het gebied van onderzoek. Vanuit mijn rol als arts wil ik dan voor de benodigde verbinding tussen de wetenschap en de praktijk zorgen.”
